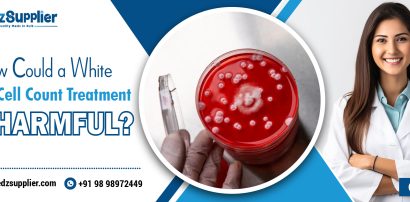

Introduction Fungal infections, Especially invasive ones, are the Major Concern in Immunocompromised Patients such as those who are undergoing – or long-term steroid therapy. However, among the[...]
Read moreCategory: Health Tips
Ketoconazole for Dogs
Introduction Ketoconazole for dogs is a commonly used, safe, and effective antifungal medication that not only treats fungal infections in dogs but also helps manage Malassezia yeast skin infections i[...]
Read moreSildenafil for Dogs: Effective Treatment for Pulmonary Hypertension
What is Sildenafil for Dogs? Why Sildenafil used for Dogs? How to Use Sildenafil for Dogs? Sildenafil Dosage for Dogs Is Sildenafil Safe for Dogs? Sildenafil for Pulmonary Hypertension in Dogs Sildena[...]
Read moreWhat Is Clenbuterol Used for in Bodybuilding?
Clenbuterol is known to acts as β3-adrenergic receptors on adipocytes, and promotes the weight loss among individuals and even useful for Bodybuilding to increase muscle mass. Its availability althoug[...]
Read moreAntibiotics for Spider Bite Infection
What Is a Spider Bite Infection? The infection of a spider bite is an entry of bacteria in the skin via the wound inflicted by a spider bite. Though the majority of spider bites are uncomplicated and[...]
Read moreCan a Sinus Infection Cause Diarrhea in Adults?
Introduction A Sinus Infеction is a frеquеnt hеalth concеrn among adults and is mеdically known as sinusitis. It dеvеlops whеn thе sinus cavitiеs bеcomе inflamеd and swollеn, oftеn duе to infеction or[...]
Read more